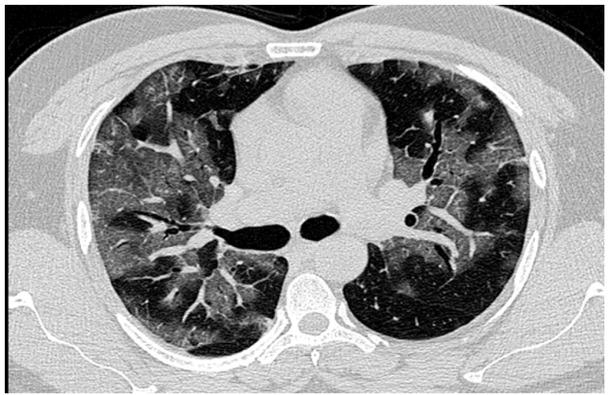
An axial section of the high resolution computed tomography chest image in a lung window showing patchy diffuse ground glass density s/o acute interstitial pneumonia.

Fig. 1A

Fig. 1B

Fig. 1C

Fig. 2A

Fig. 2B

© 2019 Bhavna P Singh, Gurucharan S Shetty, Padmakumar Arayamparambil Vijayan, Ullas Gopalakrishna, Garud Chandan, Ario Santini, Vivek Padegal, published by University of Medicine, Pharmacy, Science and Technology of Targu Mures
This work is licensed under the Creative Commons Attribution-NonCommercial-NoDerivatives 4.0 License.